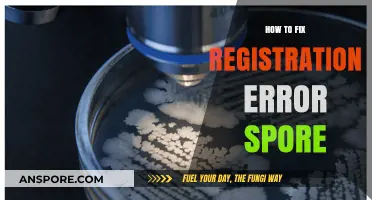
Fixing Spore Registration Errors: A Step-by-Step Troubleshooting Guide

If you're experiencing issues with *Spore* crashing on startup via Steam, you're not alone—many players encounter this frustrating problem due to outdated drivers, incompatible mods, or missing game files. Common causes include conflicts with DirectX, insufficient system resources, or corrupted Steam cache files. Fortunately, there are several troubleshooting steps you can take to resolve the issue, such as verifying game files, updating graphics drivers, disabling mods, or reinstalling DirectX. By systematically addressing these potential culprits, you can often get *Spore* running smoothly again and return to creating and evolving your unique creatures.
| Characteristics | Values |
|---|---|
| Common Causes | Outdated graphics drivers, incompatible mods, corrupted game files, insufficient system resources, or conflicts with Steam overlay. |
| Recommended Fixes | Update graphics drivers, verify game files integrity via Steam, disable mods, run the game as administrator, update DirectX and Visual C++ Redistributables, or disable Steam overlay. |
| Graphics Driver Update | Download the latest drivers from NVIDIA, AMD, or Intel's official website and install them. |
| Verify Game Files Integrity | Right-click Spore in Steam Library > Properties > Installed Files > Verify Integrity of Game Files. |
| Disable Mods | Remove or disable all mods by deleting or renaming the "Packages" folder in the Spore installation directory. |
| Run as Administrator | Right-click Spore shortcut or executable > Run as Administrator. |
| Update DirectX and Visual C++ | Install the latest DirectX End-User Runtimes and Visual C++ Redistributable packages from Microsoft's official website. |
| Disable Steam Overlay | Right-click Spore in Steam Library > Properties > General > Uncheck "Enable the Steam Overlay while in-game." |
| Compatibility Mode | Right-click Spore executable > Properties > Compatibility > Run this program in compatibility mode for Windows 7 or 8. |
| Reinstall Spore | Uninstall Spore via Steam, restart your PC, and reinstall the game. |
| Check System Requirements | Ensure your PC meets Spore's minimum requirements: Windows XP/Vista/7/8/10, 2.0 GHz CPU, 512 MB RAM, 128 MB Video Card (DX9), and 6 GB HDD space. |
| Community Solutions | Check Steam forums, Reddit, or Spore-specific communities for user-reported fixes, such as editing configuration files or using third-party patches. |
| Last Resort | Contact Steam Support or EA Support for further assistance if all other methods fail. |
Explore related products
What You'll Learn
- Verify game files integrity via Steam to ensure no corrupted files are causing crashes
- Update graphics drivers to the latest version compatible with your system
- Disable overlay apps like Discord or Steam Overlay temporarily
- Run Spore as administrator and in compatibility mode for older Windows versions
- Clear game cache and reinstall DirectX/Visual C++ Redistributables

Verify game files integrity via Steam to ensure no corrupted files are causing crashes
Corrupted game files are a common culprit behind crashes, especially on startup. Steam’s built-in file verification tool acts as a diagnostic scan, comparing your installed files against the official version stored on its servers. If discrepancies are found, Steam automatically replaces the corrupted files, restoring the game’s integrity. This process bypasses the need for manual troubleshooting or reinstallation, making it a quick and efficient first step in resolving startup crashes.
To initiate the verification process, locate *Spore* in your Steam Library and right-click on it. Select *Properties* from the dropdown menu, then navigate to the *Local Files* tab. Here, you’ll find the *Verify Integrity of Game Files* option. Click it, and Steam will begin scanning your installation. The duration of this process depends on your system’s speed and the size of the game, but it typically takes a few minutes. During this time, avoid interrupting the process to ensure all files are accurately checked and repaired.
While this method is straightforward, it’s not foolproof. If Steam fails to detect or fix corrupted files, the issue may lie elsewhere, such as outdated drivers or conflicting software. However, for many users, verifying game files resolves startup crashes immediately. It’s a low-effort, high-reward step that should always precede more complex troubleshooting methods. Think of it as a digital check-up for your game installation—quick, painless, and often effective.
One practical tip: ensure your internet connection is stable during verification, as Steam needs to download replacement files if corruption is detected. Additionally, if you’ve installed mods or custom content, back them up before running the verification, as Steam may overwrite modified files. By addressing potential file corruption early, you not only fix crashes but also ensure a smoother gaming experience overall.
Do Dry Fruits Contain Spores? Unveiling the Fungal Truth
You may want to see also

Update graphics drivers to the latest version compatible with your system
Outdated or incompatible graphics drivers are a common culprit behind game crashes, particularly at startup. *Spore*, with its complex rendering demands, relies heavily on your GPU to function smoothly. If your graphics drivers are outdated, they may lack the necessary optimizations or bug fixes required to handle the game's graphics pipeline, leading to instability and crashes.
Simply put, keeping your graphics drivers up-to-date is like giving your GPU the latest instructions on how to interpret and display *Spore*'s visual elements correctly.
Identifying the correct driver update requires knowing your GPU model and operating system. Visit the website of your GPU manufacturer (NVIDIA, AMD, or Intel) and navigate to their driver download section. Input your GPU model and operating system details to locate the latest compatible driver version. Be cautious of downloading drivers from third-party websites, as they may contain malware or incompatible software.
Stick to official sources to ensure safety and compatibility.
The driver installation process varies slightly depending on the manufacturer. Generally, it involves downloading the driver installer, running the executable file, and following the on-screen instructions. Some installers offer express or custom installation options. Opt for the express option if you're unsure, as it typically handles the installation automatically. After installation, restart your computer to apply the changes.
While updating drivers is generally safe, it's prudent to create a system restore point before proceeding. This allows you to revert to a previous system state if any issues arise after the update. Additionally, if you're using a laptop, ensure it's plugged into a power source during the installation to prevent interruptions. Finally, after updating, launch *Spore* and monitor its performance. If the crashing issue persists, consider other troubleshooting steps, such as verifying game files or adjusting graphics settings.
Can Mold Spores Trigger Strep Throat? Uncovering the Surprising Connection
You may want to see also

Disable overlay apps like Discord or Steam Overlay temporarily
Overlay applications, such as Discord or Steam Overlay, can sometimes interfere with game launches, causing crashes on startup. These overlays, while useful for communication and in-game features, may conflict with Spore’s initialization process, particularly if they attempt to hook into the game’s memory or graphics pipeline. Temporarily disabling these overlays can isolate whether they are the root cause of the crash, providing a straightforward diagnostic step before exploring more complex solutions.
To disable Discord overlay, open the Discord app, navigate to User Settings (the gear icon), select Overlay from the sidebar, and toggle off Enable in-game overlay. For Steam Overlay, right-click Spore in your Steam library, select Properties, go to the General tab, and uncheck Enable the Steam Overlay while in-game. After disabling both overlays, relaunch Spore to test if the issue persists. This process takes less than a minute and requires no technical expertise, making it an accessible first step for troubleshooting.
The rationale behind this approach lies in the way overlays interact with games. Overlays often inject code into running processes to enable features like chat or FPS counters, which can disrupt games with sensitive startup routines. Spore, being an older title, may not handle these injections gracefully, leading to crashes. By removing this variable, you can determine if the issue is external to the game itself, narrowing down potential causes and saving time on more invasive fixes like reinstalling or modifying game files.
While disabling overlays is a quick fix, it’s not always a permanent solution. If Spore runs smoothly without overlays, consider re-enabling them one at a time to identify the specific culprit. Alternatively, check for updates to both the overlay apps and Spore, as developers often release patches to resolve compatibility issues. For gamers who rely heavily on overlays, this method serves as a temporary workaround rather than a long-term solution, but it’s an essential diagnostic tool in the troubleshooting toolkit.
Mold Spores: Do They Float in Air or Settle on Surfaces?
You may want to see also
Explore related products

Run Spore as administrator and in compatibility mode for older Windows versions
Running Spore as an administrator can resolve startup crashes by granting the game unrestricted access to system resources. Modern operating systems often restrict older applications to prevent conflicts, but this safeguard can inadvertently cause issues. To apply this fix, locate the Spore executable file in your Steam library, right-click it, and select "Properties." Navigate to the "Compatibility" tab and check the box labeled "Run this program as an administrator." Confirm the changes and relaunch the game. This simple adjustment often bypasses permission-related errors that trigger crashes.
Compatibility mode is another powerful tool for stabilizing Spore on newer Windows versions. The game, originally designed for older operating systems like Windows XP or Vista, may struggle with modern architectures. By forcing compatibility, you simulate an environment the game recognizes. In the same "Compatibility" tab mentioned earlier, select "Run this program in compatibility mode for" and choose an older Windows version from the dropdown menu (Windows 7 or XP are common choices). Apply the settings and test the game. This workaround effectively bridges the gap between outdated software and contemporary hardware.
While these methods are effective, they’re not without limitations. Running Spore as an administrator may expose your system to minor security risks, though the game itself is unlikely to exploit them. Compatibility mode can occasionally introduce graphical glitches or performance quirks, as it artificially alters how the game interacts with your system. For best results, pair these fixes with ensuring your graphics drivers are up to date and disabling overlay software like Discord or Steam’s built-in features, which can interfere with older games.
In practice, combining both administrator privileges and compatibility mode often yields the most reliable results. Start by enabling compatibility mode for an older Windows version, then activate the "Run as administrator" option. If the game still crashes, experiment with different compatibility settings or consider additional troubleshooting steps, such as verifying game files through Steam. While not a guaranteed solution, this approach addresses two common culprits behind Spore’s startup crashes, making it a solid first line of defense.
Bryophytes and Their Spore-Based Life Cycle: Unveiling the Mystery
You may want to see also

Clear game cache and reinstall DirectX/Visual C++ Redistributables
Corrupted game files or missing dependencies often trigger Spore’s startup crashes on Steam. Clearing the game cache forces the system to regenerate essential files, while reinstalling DirectX and Visual C++ Redistributables ensures the game has the necessary runtime components to function. This dual approach addresses both data integrity and software compatibility, two common culprits behind such issues.
Steps to Clear Game Cache:
- Exit Steam completely, including any background processes via Task Manager.
- Navigate to the Spore installation folder (default: `C:\Program Files (x86)\Steam\steamapps\common\Spore`).
- Delete the `ClientCache` folder and any `.tmp` or `.cache` files within the directory.
- Restart Steam and verify the integrity of Spore’s game files through the Steam client (Right-click Spore > Properties > Local Files > Verify Integrity).
Reinstalling DirectX and Visual C++ Redistributables:
DirectX and Visual C++ Redistributables are critical for running games like Spore. Outdated or incomplete installations can cause crashes. Download the latest DirectX End-User Runtime from Microsoft’s official website and install it. For Visual C++ Redistributables, uninstall existing versions via Control Panel > Programs > Programs and Features, then download the latest all-in-one installer from Microsoft, ensuring both x86 and x64 versions are included.
Cautions and Practical Tips:
Avoid manually deleting system files outside the game directory, as this can destabilize other applications. Always restart your PC after reinstalling dependencies to ensure changes take effect. If DirectX installation fails, run the installer as an administrator or in compatibility mode for Windows 7.
Clearing the game cache and reinstalling DirectX/Visual C++ Redistributables is a targeted solution that resolves Spore’s startup crashes by refreshing corrupted files and ensuring compatibility. While it requires careful execution, this method is effective for users facing persistent issues tied to missing or outdated system components.
Do Protists Use Spores? Unveiling Their Unique Reproductive Strategies
You may want to see also
Frequently asked questions
Spore may crash on startup due to outdated graphics drivers, incompatible mods, or missing/corrupted game files. Ensure your graphics drivers are up to date, disable any mods, and verify the integrity of the game files through Steam.
Right-click Spore in your Steam library, select "Properties," go to the "Local Files" tab, and click "Verify Integrity of Game Files." Steam will check and repair any missing or corrupted files, which may resolve the crashing issue.
Try running Spore in compatibility mode for an older version of Windows (e.g., Windows 7 or 8). Right-click the game executable, go to "Properties," select the "Compatibility" tab, and choose the appropriate setting. Additionally, ensure your system meets the minimum requirements for the game.